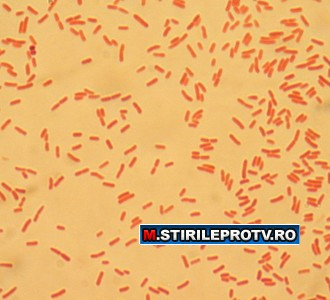
Epidemie in Germania. O bacterie contagioasa a ucis 2 oameni. Cum se transmite

Europa isi despagubeste neputinta. Milioane de euro pentru castravetii dati la gunoi. E.coli rezista
Isteria E.coli prinde puteri tot mai mari: acum a ajuns si in Canada si a mai ucis trei oameni, dintre care o fetita de ...
Citeste mai mult ›
Citeste mai mult ›